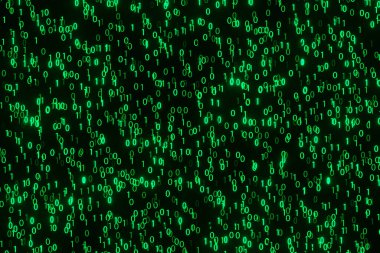
Siyah arkaplana yağan yeşil parlayan ikili değerler. Bilgisayar kodlama ve dijital teknoloji konsepti için illüstrasyon

Bulanık, yeşil kumaş parlayan bir parıltıyla soyut desenlere sahip, görsel olarak büyüleyici bir doku yaratıyor. İç içe geçmiş kumaş ve ışık yansımaları sanatsal ve modern bir his uyandırıyor..
İhlal Bildirim Formu

Özel Boyut
(4900 x 2000, jpg)
Geniş Lisanslama
(4900 x 2000, jpg)
* Kurumsal aylık abonelikte çok avantajlı fiyatlar için tıklayın.
* Fiyatlara Kdv dahil değildir.
Örnek Kullanımlar: Web siteleri; reklam afişleri; ekran koruyucuları; sunumlar (PowerPoint, Flash, vs); filmler, videolar veya televizyon reklamları, gazete ve dergilerdeki reklamlar, bastırılmış reklam materyalleri; kitaplar için kapak, iş kartları; el ilanları; posterler; CD/DVD kapakları, etiketler veya ürün paketleri, kırtasiye, dosya, defterler, tükenmez kalem, kalemler, yapıştırmalar; takvimler; fincanlar veya bardaklar; fare altlığı; tişörtler, kıyafet vs. Detaylı Tablo için Tıklayınız!
En Çok Aranan Kelimeler
ParlaModern Tasarımsoyut desenkumaş deseniKumaş dokusukumaş sanatıYeşil Soyutparlak yüzeyışık yansımasıTekstil desenyeşil malzemeYeşil Desenyeşil tasarımYeşil kumaşYeşil Tekstilsanatsal dokusanatsal ışığısanatsal kumaşDesen Dokusuyaratıcı soyutparlayan etkisidoku sanatyeşil sanattekstil sanatıyeşil parıltıkumaş kompozisyoncreative fabricsoyut Parlatıcıfabric foldkumaş detayparlak tasarımmodern textilesoyut parlayanfabric close upart fabricYeşil soyut dokutextile foldstextile close upparlayan kumaşparlayan maddeyansıtıcı kumaştextile shinelight detailsfabric lightingfabric lightabstract textile designglowing threadsBenzer İçerikler


Özel Boyut
(4900 x 2000, jpg)
Geniş Lisanslama
(4900 x 2000, jpg)
Eser Sahibi:
Tarih:
Warning: substr_count(): Empty substring in /home/lisansio/public_html/wp-content/themes/telifport_v3/inc-frontend/modal-urun-bilgileri.php on line 288